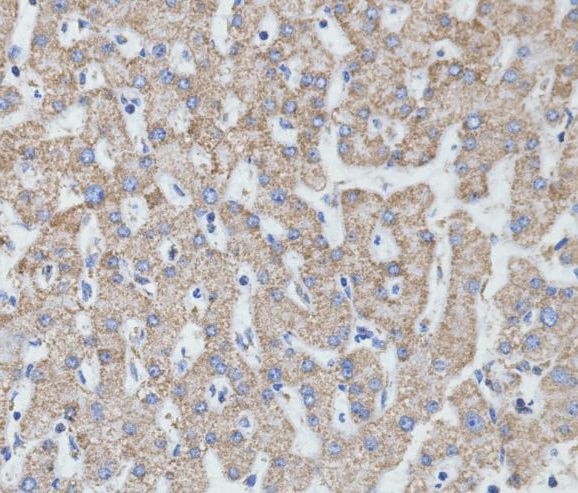

-
分类: 科研抗体货号: P22809别名: PHA; LMN2R; TDRD18; DHCR14B; LBR应用: WB,IP,IHC,IF反应种属: Human,Rat
-
分类: 科研抗体货号: P22808别名: ACLY; ATP-citrate synthase; ATP-citrate; pro-S-)-lyase; ACL; Citrate cleavage enzyme应用: WB,IP,IHC,IF,FCM反应种属: Human,Mouse,Rat
-
分类: 科研抗体货号: P22824别名: Catenin alpha-1; Alpha E-catenin; Cadherin-associated protein; Renal carcinoma antigen NY-REN-13应用: WB,IP,IHC,IF,FCM反应种属: Human,Mouse,Rat
-
分类: 科研抗体货号: P22807别名: CCR3; CMKBR3; C-C chemokine receptor type 3; C-C CKR-3; CC-CKR-3; CCR-3; CCR3; CKR3; Eosinophil eotaxin receptor; CD193应用: WB,IHC,IF反应种属: Human,Mouse,Rat
-
分类: 科研抗体货号: P22838别名: MT-CO2; COX2; CO2; Cytochrome c oxidase II; MTCO2; COII; COXII应用: WB,IP,IHC,IF,FCM反应种属: Human
-
分类: 科研抗体货号: P22823别名: CTTN; EMS1; Src substrate cortactin; Amplaxin; Oncogene EMS1应用: WB,IP,IHC,IF,FCM反应种属: Human,Mouse,Rat
-
分类: 科研抗体货号: P22832别名: SMAC; DFNA64; DIABLO; SMAC3应用: WB,IP,IHC,IF,FCM反应种属: Human,Mouse,Rat
-
分类: 科研抗体货号: P22837别名: PTGS1; COX1; Prostaglandin G/H synthase 1; Cyclooxygenase-1; COX-1; Prostaglandin H2 synthase 1; PGH synthase 1; PGHS-1; PHS 1; Prostaglandin-endoperoxide synthase 1应用: WB,IP,IHC,IF,FCM反应种属: Human,Mouse,Rat
-
分类: 科研抗体货号: P22822别名: GAP43; Neuromodulin; Axonal membrane protein GAP-43; Growth-associated protein 43; Neural phosphoprotein B-50; pp46应用: WB,IP,IHC,IF,FCM反应种属: Human,Mouse,Rat
-
分类: 科研抗体货号: P22831别名: ANGPT1; KIAA0003; Angiopoietin-1; ANG-1应用: WB反应种属: Human,Rat

鄂公网安备42018502007531号
鄂公网安备42018502007531号

